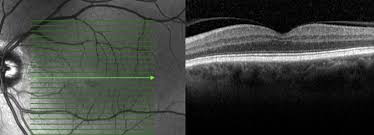

Afinal, o que são traumas oculares? Descubra!
Sabemos que o olho é uma estrutura bastante delicada e, mesmo protegido por outras estruturas, está suscetível a lesões que são conhecidas como traumas oculares. Eles
Sabemos que o olho é uma estrutura bastante delicada e, mesmo protegido por outras estruturas, está suscetível a lesões que são conhecidas como traumas oculares. Eles

Ele ajuda a reduzir a vermelhidão, aliviar uma alergia e a tratar a conjuntivite bacteriana. Hoje em dia, o colírio para os olhos faz muito mais do que a

Saiba mais sobre essa condição clínica, o procedimento para tratamento e sua importância O que é a catarata? A catarata é uma situação clínica na qual ocorre
Se para você é difícil enxergar os objetos com nitidez quando eles estão longe, existem enormes chances de você ser míope. Essa condição é bastante comum —

A vermelhidão nos olhos pode ser causada por diversos fatores, desde um cisco no olho a inflamações mais sérias. Geralmente, ela é resultado da dilatação de
Sabemos que o olho é uma estrutura bastante delicada e, mesmo protegido por outras estruturas, está suscetível a lesões que são conhecidas como traumas oculares. Eles
O seu canal de atendimento e suporte para buscar cirurgias e tratamentos oftalmológicos com valores acessíveis.
